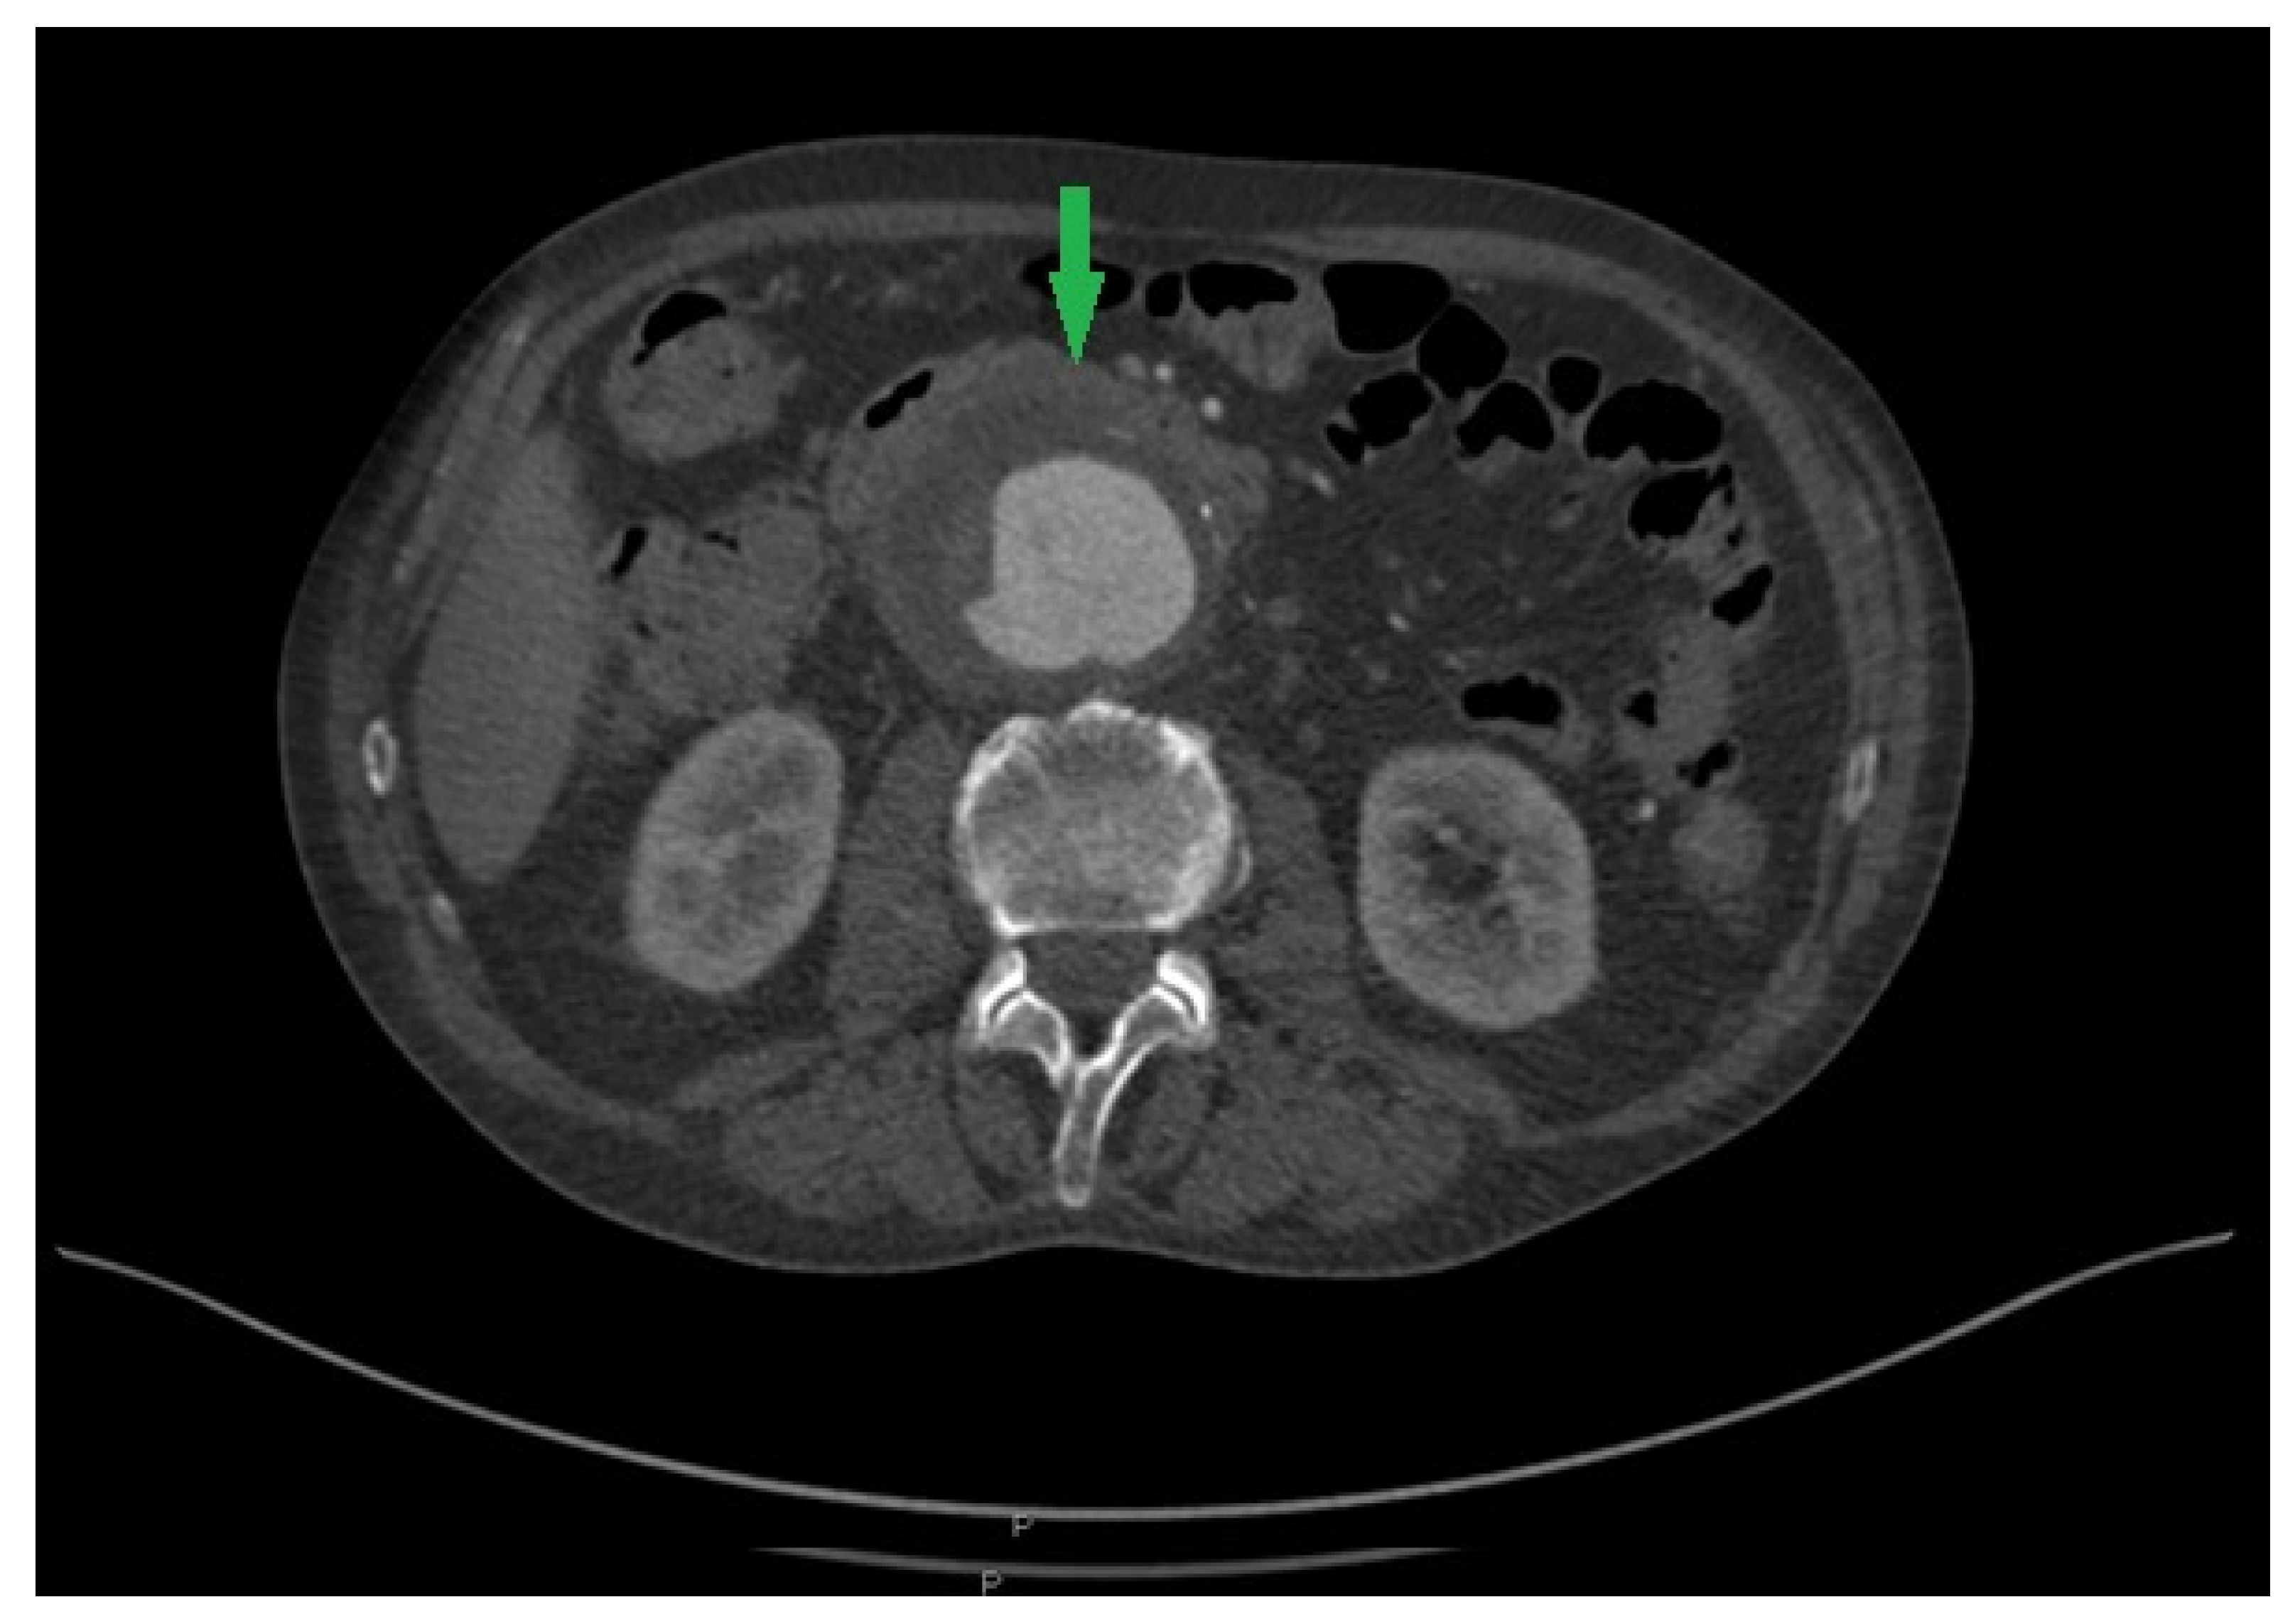
Pathogens 13 00805 g001 Pathogens 13 00805 g001

First Case Report of Mycotic Abdominal Aortic Aneurysm Caused by Campylobacter fetus in Serbia
Abstract
1. Introduction
2. Case Report
3. Discussion
4. Conclusions
Author Contributions
Funding
Institutional Review Board Statement
Informed Consent Statement
Data Availability Statement
Acknowledgments
Conflicts of Interest
References
- Nelson, J.M.; Chiller, T.M.; Powers, J.H.; Angulo, F.J. Fluoroquinolone-resistant Campylobacter species and the withdrawal of fluoroquinolones from use in poultry: A public health success story. Clin. Infect. Dis. 2007, 44, 977–980. [Google Scholar] [CrossRef] [PubMed]
- Adhikari, P.; Antala, D.; Bhandari, B.; Mohamed, K.; Egoryan, G.; Stake, J.J.; Friedman, H. A case of Campylobacter fetus subspecies fetus systemic infection. Cureus 2022, 14, e23963. [Google Scholar] [CrossRef] [PubMed]
- Allos, B.M. Campylobacter jejuni infections: Update on emerging issues and trends. Clin. Infect. Dis. 2001, 32, 1201–1206. [Google Scholar] [CrossRef]
- Abdel-Glil, M.Y.; Hotzel, H.; Tomaso, H.; Didelot, X.; Brandt, C.; Seyboldt, C.; Linde, J.; Schwarz, S.; Neubauer, H.; El-Adawy, H. Genomic epidemiology of Campylobacter fetus subsp. venerealis from Germany. Front. Vet. Sci. 2023, 9, 1069062. [Google Scholar] [CrossRef] [PubMed]
- Kienesberger, S.; Gorkiewicz, G.; Wolinski, H.; Zechner, E.L. New molecular microbiology approaches in the study of Campylobacter fetus. Microb. Biotechnol. 2011, 4, 8–19. [Google Scholar] [CrossRef]
- Gilbert, M.J.; Miller, W.G.; Yee, E.; Blaser, M.J.; Wagenaar, J.A.; Duim, B. Complete genome sequence of Campylobacter fetus subsp. testudinum strain 03-427T. Genome. Announc. 2013, 1, e01002-13. [Google Scholar] [CrossRef]
- Wagenaar, J.A.; van Bergen, M.A.; Blaser, M.J.; Tauxe, R.V.; Newell, D.G.; van Putten, J.P. Campylobacter fetus infections in humans: Exposure and disease. Clin. Infect. Dis. 2014, 58, 1579–1586. [Google Scholar] [CrossRef]
- Cypierre, A.; Denes, E.; Barraud, O.; Jamilloux, Y.; Jacques, J.; Durox, H.; Pinet, P.; Weinbreck, P. Campylobacter fetus infections. Med. Mal. Infect. 2014, 44, 167–173. [Google Scholar] [CrossRef]
- Noda, Y.; Sawada, K.; Yoshida, S.H.; Nishida, S.; Yamamoto, S.; Otake, Y.; Watanabe, G. Mycotic abdominal aneurysm caused by Campylobacter fetus: A case report for surgical management. Ann. Vasc. Dis. 2011, 4, 56–59. [Google Scholar] [CrossRef]
- Wanhainen, A.; Van Herzeele, I.; Goncalves, F.B.; Montoya, S.B.; Berard, H.; Boyle, J.R.; D’Oria, M.; Prendes, C.F.; Karkos, C.D.; Kazimierczak, A.; et al. Editor’s Choice–European Society for Vascular Surgery (ESVS) 2024 Clinical Practice Guidelines on the Management of Abdominal Aorto-Iliac Artery Aneurysms. Eur. J. Vasc. Endovasc. Surg. 2024, 67, 192–331. [Google Scholar]
- Maeda, H.; Umezawa, H.; Goshima, M.; Hattori, T.; Nakamura, T.; Umeda, T.; Shiono, M. Primary infected abdominal aortic aneurysm: Surgical procedures, early mortality rates, and a survey of the prevalence of infectious organisms over a 30-year period. Surg. Today 2011, 41, 346–351. [Google Scholar] [CrossRef]
- Brown, S.L.; Busuttil, R.W.; Baker, J.D.; Machleder, H.I.; Moore, W.S.; Barker, W.F. Bacteriologic and surgical determinants of survival in patients with mycotic aneurysms. J. Vasc. Surg. 1984, 1, 541–547. [Google Scholar] [CrossRef] [PubMed]
- Cochennec, F.; Gazaigne, L.; Lesprit, P.; Desgranges, P.; Allaire, E.; Becquemin, J.P. Aortoiliac aneurysms infected by Campylobacter fetus. J. Vasc. Surg. 2008, 48, 815–820. [Google Scholar] [CrossRef] [PubMed]
- Raavi, L.; Garg, P.; Hussain, M.W.A.; Wadiwala, I.J.; Mateen, N.T.; Elawady, M.S.; Alomari, M.; Alamouti-Fard, E.; Pham, S.M.; Jacob, S. Mycotic Thoracic Aortic Aneurysm: Epidemiology, Pathophysiology, Diagnosis, and Management. Cureus 2022, 14, e31010. [Google Scholar] [CrossRef] [PubMed]
- Matsui, K.; Takahashi, K.; Tashiro, M.; Tanaka, T.; Izumikawa, K.; Miura, T.; Eishi, K.; Furumoto, A.; Ariyoshi, K. Clinical and microbiological characteristics and challenges in diagnosing infected aneurysm: A retrospective observational study from a single center in Japan. BMC Infect. Dis. 2022, 22, 585. [Google Scholar] [CrossRef]
- Public Health England. Identification of Campylobacter Species. UK Standards for Microbiology Investigations. 2018, ID 23i3.1, 1–24. Available online: https://www.rcpath.org/profession/publications/standards-for-microbiology-investigations/identification.html (accessed on 2 November 2022).
- Public Health England. Investigation of Tissues and Biopsies from Deep-Seated Sites and Organs. UK Standards for Microbiology Investigations. 2018, B 17i6.3, 1–26. Available online: https://www.rcpath.org/profession/publications/standards-for-microbiology-investigations/bacteriology.html (accessed on 2 November 2022).
- Klein, B.S.; Vergeront, J.M.; Blaser, M.J.; Edmonds, P.; Brenner, D.J.; Janssen, D.; Davis, J.P. Campylobacter infection associated with raw milk: An outbreak of gastroenteritis due to Campylobacter jejuni and thermotolerant Campylobacter fetus subsp fetus. JAMA 1986, 255, 361–364. [Google Scholar] [CrossRef] [PubMed]
- Woo, P.C.; Leung, K.W.; Tsoi, H.W.; Wong, S.S.; Teng, J.L.; Yuen, K.Y. Thermo-tolerant Campylobacter fetus bacteraemia identified by 16S ribosomal RNA gene sequencing: An emerging pathogen in immunocompromised patient. J. Med. Microbiol. 2002, 51, 740–746. [Google Scholar] [CrossRef] [PubMed][Green Version]
- Hum, S.; Quinn, K.; Brunner, J.; On, S.L. Evaluation of PCR assay for identification and differentiation of Campylobacter fetus subspecies. Aust. Vet. J. 1997, 75, 827–831. [Google Scholar] [CrossRef]
- Tinévez, C.; Lehours, P.; Ranc, A.G.; Belaroussi, Y.; Velardo, F.; Dubois, D.; Neuwirth, C.; Pailhoriès, H.; Dorel, M.; Hery-Arnaud, G.; et al. Multicenter retrospective study of vascular infections and endocarditis caused by Campylobacter spp., France. Emerg. Infect. Dis. 2023, 29, 484–492. [Google Scholar] [CrossRef]
- Ghimire, R.; Urban, C.; Lee, A.; Pokhrel, A.; Wehbeh, W.; Turett, G. Campylobacter fetus infection of the aorta: A case report and review of literature. Am. J. Infect. Dis. 2015, 11, 26–32. [Google Scholar] [CrossRef][Green Version]
- Zayet, S.; Klopfenstein, T.; Gendrin, V.; Vuillemenot, J.B.; Plantin, J.; Toko, L.; Sreiri, N.; Royer, P.Y. Campylobacter fetus invasive infections and risks for death, France, 2000–2021. Emerg. Infect. Dis. 2023, 29, 2189–2197. [Google Scholar] [CrossRef] [PubMed]
- Kaakoush, N.O.; Castaño-Rodríguez, N.; Mitchell, H.M.; Man, S.M. Global epidemiology of Campylobacter infection. Clin. Microbiol. Rev. 2015, 28, 687–720. [Google Scholar] [CrossRef]
- Ahtesham, A.S.; Wajahat, A.S. Review of food-borne microorganism: Campylobacter species. J. Food Microbiol. Saf. Hyg. 2019, 4, 141. Available online: https://www.longdom.org/open-access/review-of-foodborne-microorganism-emcampylobacterem-species.pdf (accessed on 2 November 2022).
- Dobrović, K.; Fila, B.; Janeš, A.; Civljak, R. Campylobacter fetus bacteremia related to vascular prosthesis and pseudoaneurysm infection: A case report and review. Pathogens 2022, 11, 1536. [Google Scholar] [CrossRef]
- Müller, B.T.; Wegener, O.R.; Grabitz, K.; Pillny, M.; Thomas, L.; Sandmann, W. Mycotic aneurysms of the thoracic and abdominal aorta and iliac arteries: Experience with anatomic and extra-anatomic repair in 33 cases. J. Vasc. Surg. 2001, 33, 106–113. [Google Scholar] [CrossRef]
- Blanchard, J.F. Epidemiology of abdominal aortic aneurysms. Epidemiol. Rev. 1999, 21, 207–221. [Google Scholar] [CrossRef]
- Blaser, M.J.; Smith, P.F.; Repine, J.E.; Joiner, K.A. Pathogenesis of Campylobacter fetus infections. Failure of encapsulated Campylobacter fetus to bind C3b explains serum and phagocytosis resistance. J. Clin. Invest. 1988, 81, 1434–1444. [Google Scholar] [CrossRef] [PubMed]
- Morrison, V.A.; Lloyd, B.K.; Chia, J.K.; Tuazon, C.U. Cardiovascular and bacteremic manifestations of Campylobacter fetus infection: Case report and review. Rev. Infect. Dis. 1990, 12, 387–392. [Google Scholar] [CrossRef] [PubMed]
- Geissler, A.L.; Bustos, F.B.; Swanson, K.; Patrick, M.E.; Fullerton, K.E.; Bennett, C.; Barrett, K.; Mahon, B.E. Increasing Campylobacter Infections, outbreaks, and antimicrobial resistance in the United States, 2004–2012. Clin. Infect. Dis. 2017, 65, 1624–1631. [Google Scholar] [CrossRef]
- Petridou, C.; Strakova, L.; Simpson, R. Campylobacter fetus prosthetic valve endocarditis presenting as a stroke. JMM Case Rep. 2018, 5, e005147. [Google Scholar] [CrossRef]
- Ledina, D.; Ivić, I.; Karanović, J.; Karanović, N.; Kuzmičić, N.; Ledina, D.; Puljiz, Z. Campylobacter fetus infection presenting with bacteremia and cellulitis in a 72-year-old man with an implanted pacemaker: A case report. J. Med. Case Rep. 2012, 6, 414. [Google Scholar] [CrossRef] [PubMed]
- Coustillères, F.; Hanoy, M.; Lemée, L.; Le Roy, F.; Bertrand, D. Campylobacter fetus bacteremia complicated by multiple splenic abscesses and multivisceral signs in a renal transplant recipient: A case report and review of the literature. Braz. J. Infect. Dis. 2022, 26, 102336. [Google Scholar] [CrossRef] [PubMed]
- Nakatani, R.; Shimizu, K.; Matsuo, T.; Koyamada, R.; Mori, N.; Yamashita, T.; Mori, S. Campylobacter fetus bacteremia and meningitis in an acute lymphoblastic leukemia patient undergoing maintenance therapy: A case report. BMC Infect. Dis. 2021, 21, 680. [Google Scholar] [CrossRef] [PubMed]
- The European Committee on Antimicrobial Susceptibility Testing. Breakpoint Tables for Interpretation of MICs and Zone Diameters; Version 12.0; EUCAST: Växjö, Sweden, 2022. [Google Scholar]
- Vandenberg, O.; Houf, K.; Douat, N.; Vlaes, L.; Retore, P.; Butzler, J.P.; Dediste, A. Antimicrobial susceptibility of clinical isolates of non-jejuni/coli campylobacters and arcobacters from Belgium. J. Antimicrob. Chemother. 2006, 57, 908–913. [Google Scholar] [CrossRef][Green Version]
- Tremblay, C.; Gaudreau, C. Antimicrobial susceptibility testing of 59 strains of Campylobacter fetus subsp. fetus. Antimicrob. Agents Chemother. 1998, 42, 1847–1849. [Google Scholar] [CrossRef][Green Version]
- Bulajić, N.; Miljković-Selimović, B.; Tambur, Z.; Kocić, B.; Kalevski, K.; Aleksić, E. Prevalence of antimicrobial resistance in Campylobacter spp.: A review of the literature. Acta Microbiol. Immunol. Hung. 2021, 69, 2022. [Google Scholar] [CrossRef]
Disclaimer/Publisher’s Note: The statements, opinions and data contained in all publications are solely those of the individual author(s) and contributor(s) and not of MDPI and/or the editor(s). MDPI and/or the editor(s) disclaim responsibility for any injury to people or property resulting from any ideas, methods, instructions or products referred to in the content. |
© 2024 by the authors. Licensee MDPI, Basel, Switzerland. This article is an open access article distributed under the terms and conditions of the Creative Commons Attribution (CC BY) license (https://creativecommons.org/licenses/by/4.0/).
Share and Cite
Medic, D.; Devrnja, M.; Batinic, N.; Milosevic, D.; Colovic Popadic, A.; Gusman, V. First Case Report of Mycotic Abdominal Aortic Aneurysm Caused by Campylobacter fetus in Serbia. Pathogens 2024, 13, 805. https://doi.org/10.3390/pathogens13090805
Medic D, Devrnja M, Batinic N, Milosevic D, Colovic Popadic A, Gusman V. First Case Report of Mycotic Abdominal Aortic Aneurysm Caused by Campylobacter fetus in Serbia. Pathogens. 2024; 13(9):805. https://doi.org/10.3390/pathogens13090805
Chicago/Turabian StyleMedic, Deana, Milica Devrnja, Nikola Batinic, Djordje Milosevic, Aleksandra Colovic Popadic, and Vera Gusman. 2024. "First Case Report of Mycotic Abdominal Aortic Aneurysm Caused by Campylobacter fetus in Serbia" Pathogens 13, no. 9: 805. https://doi.org/10.3390/pathogens13090805
APA StyleMedic, D., Devrnja, M., Batinic, N., Milosevic, D., Colovic Popadic, A., & Gusman, V. (2024). First Case Report of Mycotic Abdominal Aortic Aneurysm Caused by Campylobacter fetus in Serbia. Pathogens, 13(9), 805. https://doi.org/10.3390/pathogens13090805





